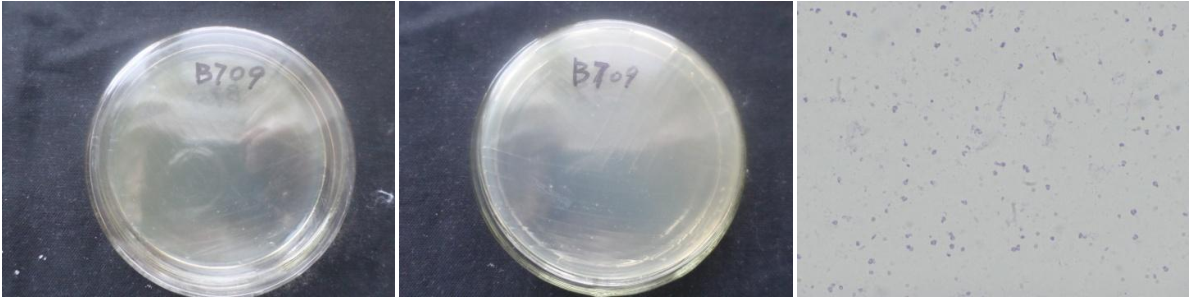

Loading...
| StrainNO | B709 |
| Classification | Planococcaceae_incertae_sedis |
| 16s rDNA sequence | TGACGGGGCGGCGTGCTATACATGCAAGTCGAGCGGACTTGATGGGAGCTTGCTCCTTATCAAGTTAGCGGCGGACGGGTGAGTA ACACGTGGGCAACCTGCCCTATAGTTGGGGATAACTCCGGGAAACCGGGGCTAATACCGAATAATACATTTCTTCTCCTGATGAA ATGTTGAAAGATGGTTTACGCTATCGCTATAGGATGGGCCCGCGGCGCATTAGCTAGTTGGTGAGGTAACGGCTCACCAAGGCGA CGATGCGTAGCCGACCTGAGAGGGTGATCGGCCACACTGGGACTGAGACACGGCCCAGACTCCTACGGGAGGCAGCAGTAGGGAA TCTTCCACAATGGGCGAAAGCCTGATGGAGCAACGCCGCGTGAGTGAAGAAGGTTTTCGGATCGTAAAACTCTGTTGTAAGGGAA GAACAAGTACAGTAGTAACTGGCTGTACCTTGACGGTACCTTATTAGAAAGCCACGGCTAACTACGTGCCAGCAGCCGCGGTAAT ACGTAGGTGGCAAGCGTTGTCCGGAATTATTGGGCGTAAAGCGCGCGCAGGTGGTCCTTTAAGTCTGATGTGAAAGCCCACGGCT CAACCGTGGAGGGTCATTGGAAACTGGGGGACTTGAGTGCAGAAGAGGAAAGTGGAATTCCAAGTGTAGCGGTGAAATGCGTAGA GATTTGGAGGAACACCAGTGGCGAAGGCGACTTTCTGGTCTGTAACTGACACTGAGGCGCGAAAGCGTGGGGAGCAAACAGGATT AGATACCCTGGTAGTCCACGCCGTAAACGATGAGTGCTAAGTGTTAGGGGGTTTCCGCCCCTTAGTGCTGCAGCTAACGCATTAA GCACTCCGCCTGGGGAGTACGGTCGCAAGACTGAAACTCAAAGGAATTGACGGGGGCCCGCACAAGCGGTGGAGCATGTGGTTTA ATTCGAAGCAACGCGAAGAACCTTACCAGGTCTTGACATCCCATTGACCGCTATGGAGACATAGCTTTCCCTTCGGGGACAGTGG TGACAGGTGGTGCATGGTTGTCGTCAGCTCGTGTCGTGAGATGTTGGGTTAAGTCCCGCAACGAGCGCAACCCTTGTTCTTAGTT GCCATCATTTAGTTGGGCACTCTAAGGAGACTGCCGGTGACAAACCGGAGGAAGGTGGGGATGACGTCAAATCATCATGCCCCTT ATGACCTGGGCTACACACGTGCTACAATGGACGGTACAAACGGTTGCCAACCCGCGAGGGGGAGCTAATCCGATAAAACCGTTCT CAGTTCGGATTGTAGGCTGCAACTCGCCTACATGAAGCCGGAATCGCTAGTAATCGCGGATCAGCATGCCGCGGTGAATACGTTC CCGGGCCTTGTACACACCGCCCGTCACACCACGAGAGTTTGTAACACCCGAAGCCGGTGGGGTAACCCTTTTGGGAGCCAGCCGT CGAAGGGTGAACAAGAAC |
| Strain Morphology Photos | |
| Morphological Description | Colony round;Lychee flesh white;edge neatly;steamed bun shaped;slippy;sticky;Rod;having spore;Bacteriophage telogen |